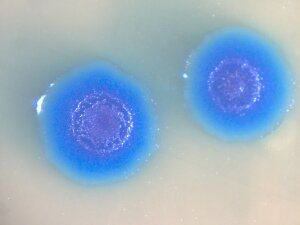

|
Американские ученые провели первую в мире успешную операцию по пересадке целого генома от одного вида бактерий к другому. В результате микробы приобрели все свойства того вида, чей геном был им пересажен. Успех этого эксперимента — важный шаг на пути к созданию искусственных живых организмов.
Ученые из Института Крейга Вентера (J. Craig Venter Institute) в течение последних 10 лет уверенно идут к великой цели — созданию искусственных микроорганизмов с заданными свойствами. Практическое значение этих работ может оказаться огромным. Например, планируется создание микробов, которые будут в больших количествах производить дешевое топливо. Генеральная идея состоит в том, чтобы установить минимальный набор генов, необходимый для жизнеобеспечения бактерии, добавить туда гены, кодирующие полезные функции (например, синтез водорода), искусственно синтезировать спроектированный геном и внедрить его в живую бактерию, собственный геном которой должен быть каким-то образом удален.Работы ведутся в основном с бактериями рода Mycoplasma. Это довольно обширная (около 180 видов) группа паразитических бактерий, вызывающих всевозможные болезни у растений, животных и человека. Микоплазмы обладают рядом уникальных свойств, которые делают их весьма удобным объектом для подобных исследований. Геномы микоплазм очень малы (от 600 до 1400 тыс. пар оснований) и хорошо изучены — на сегодняшний день полностью прочтены геномы 14 видов. В отличие от подавляющего большинства других бактерий с маленькими геномами, микоплазмы не являются облигатными внутриклеточными паразитами — они могут жить вне хозяйских клеток, поэтому их можно выращивать обычным образом на питательной среде. Правда, среда должна быть весьма богатой — микоплазмы очень требовательны в этом отношении, поскольку у них отсутствуют гены, необходимые для синтеза многих жизненно важных веществ. Наконец, у микоплазм нет жесткой клеточной стенки, характерной для подавляющего большинства бактерий. Клетки микоплазм окружены лишь тонкой и эластичной плазматической мембраной. Это сильно облегчает обмен наследственным материалом между клетками.
|
Изучая геномы микоплазм, Крейг Вентер и его коллеги уже очень близко подошли к пониманию того, что должен представлять собой «минимальный геном» будущих искусственных микробов. Синтез искусственных фрагментов генома уже налажен, синтез целого бактериального генома — дело недалекого будущего. Однако до сих пор никому не удавалось пересадить целый геном в живую бактериальную клетку. Отдельные фрагменты геномов пересаживают давно, и в этом ученым большую помощь оказывают имеющиеся у бактерий естественные механизмы для обмена генетическим материалом. Такой обмен в мире бактерий осуществляется тремя основными путями:
-
конъюгация: две бактерии соединяются при помощи специальных белковых трубочек — пилей, и бактерия-донор передает бактерии-реципиенту часть своего генома;
-
вирусная трансдукция: вирусы, переходя из одной клетки в другую, могут прихватывать с собой куски бактериального генома;
-
естественная трансформация: иногда бактерия просто «всасывает» фрагменты ДНК из окружающей среды и, при определенных условиях, встраивает их в свой геном.
Однако во всех этих случаях речь идет о передаче лишь сравнительно небольших кусочков генома.
В статье, опубликованной 28 июня на сайте журнала Science, Крейг Вентер (Craig Venter) и его сотрудники сообщили о первой успешной трансплантации целого генома от одного вида бактерий другому. Правда, ученые пока сами не до конца понимают, как им это удалось, и пройдет ли этот номер с другими видами бактерий. Сделано было следующее. Ученые выделили геном из бактерии Mycoplasma mycoides, которая вызывает тяжелую пневмонию у коров и может заражать других парнокопытных. Геном этого микроба, как и у большинства бактерий, представляет собой одну кольцевую молекулу ДНК. Геном был тщательно очищен от посторонних примесей, в том числе от белков, и добавлен в культуру бактерий Mycoplasma capricolum, возбудителей козьего полиартрита, которые поражают также коров и овец. Предварительно в геном M. mycoides были внесены особые метки — в том числе гены устойчивости к антибиотикам — чтобы легче было потом определить, успешно ли прошла трансплантация.
|
Спустя недолгое время среди клеток Mycoplasma capricolum появились бактерии с признаками Mycoplasma mycoides. Обработав культуру бактерий антибиотиком, ученые уничтожили тех микробов, которые не вобрали в себя чужую ДНК, а оставшихся подвергли тщательному изучению. По всем признакам это были самые настоящие M. mycoides. Ни генов, ни белков, характерных для исходного вида Mycoplasma capricolum, у них обнаружить не удалось. Антитела, избирательно реагирующие на поверхностные белки Mycoplasma capricolum, не прикреплялись к этим микробам, в отличие от антител, распознающих поверхностные белки Mycoplasma mycoides (синяя окраска колоний на снимке сигнализирует об успехе одного из таких иммунологических тестов).
Всё это свидетельствует о том, что пересадка генома полностью удалась. Авторы не знают точно, как это произошло, но предполагают, что бактерии «проглатывали» чужую молекулу ДНК, и в первый момент в них, вероятно, содержались оба генома вместе. Когда такая клетка делилась, одна из дочерних клеток получала геном Mycoplasma capricolum, а другая — геном Mycoplasma mycoides. Последующая обработка антибиотиком уничтожила клетки первого типа.
Дальнейшие исследования покажут, можно ли проделывать подобную манипуляцию с другими бактериями-реципиентами и другими геномами. Не исключено, что вобрать в себя целый чужой геном способны только микробы, не имеющие клеточной стенки — в этом случае микоплазмы, скорее всего, и впредь останутся единственными объектами для таких экспериментов. Так или иначе, проделанная работа сильно приблизила Крейга Вентера к его заветной цели — созданию искусственного микроба. По-видимому, эта цель может быть достигнута уже через несколько лет. Кстати сказать, в США сейчас активно дискутируются этические и юридические проблемы, связанные с близящимся созданием искусственных организмов. Самые горячие споры идут по вопросу о том, можно ли будет эти организмы патентовать.